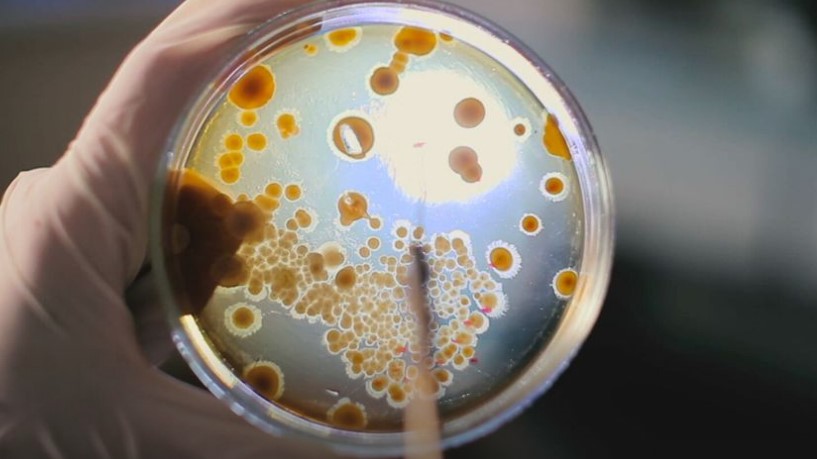
Rekordan broj slučajeva raka u Britaniji: Dijagnostikuje se na svakih 80 sekundi

FOTO: DNEVNIK.HR
FOTO: DNEVNIK.HR
Rekordan broj slučajeva raka u Britaniji: Dijagnostikuje se na svakih 80 sekundi
23.04.2026. | 12:35Broj oboljelih od raka u Velikoj Britaniji dostigao je rekordni nivo, pokazuje istraživanje organizacije Kanser riserč UK u kojem se navodi da se kod više od 403.000 ljudi dijagnostikuje svake godine neki oblik raka, što znači da se bolest otkrije kod jedne osobe približno na svakih 80 sekundi.
U izvještaju se navodi da je porast posljedica “starenja i rasta populacije”, prenosi Skaj njuz.
Stope obolijevanja porasle su za 15 odsto od početka 1990-ih, djelimično zbog faktora kao što je gojaznost.
Izvršna direktorka ove humanitarne organizacije Mišel Mičel izjavila je da se rak dijagnostikuje kod više ljudi nego ikada.
Ona je navela da se, iako se preživljavanje od raka udvostručilo od 1970-ih, napredak u posljednjoj deceniji usporio.
Mičel je dodala da bi nedavno objavljeni Nacionalni plan za borbu protiv raka mogao da donese značajne promjene, ali samo ako se pretvori u konkretna poboljšanja za pacijente.
Izvještaj “Rak u Britaniji 2026” ocjenjuje da je plan za Englesku ključan korak ka unapređenju liječenja, ali upozorava da su potrebna dodatna sredstva i resursi kako bi se “ambicije pretvorile u rezultate”.
Organizacija upozorava da su potrebne hitne mjere za rano otkrivanje bolesti, ističući da se nešto više od polovine pacijenata u Velikoj Britaniji dijagnostikuje u ranoj fazi, pri čemu se taj procenat godinama gotovo ne mijenja.
Preporučuje se i širenje programa skrininga pluća, što bi moglo da omogući otkrivanje do 7.800 dodatnih slučajeva raka godišnje, ukoliko se programi u Engleskoj optimizuju.
Kanser riserč UK, takođe, poziva na jačanje prevencije, navodeći da je od ključnog značaja da se Zakon o duvanu i vejpovima dosljedno primjeni.
Tim zakonom bi se zabranila prodaja cigareta osobama rođenim nakon 2008. godine.
Organizacija, takođe, predlaže ulaganja u specijalizovano osoblje i opremu kako bi se smanjile liste čekanja, uz podatak da je oko 107.000 pacijenata u 2025. godini čekalo više od 62 dana na početak liječenja.
Portparol britanskog Ministarstva zdravlja i socijalne zaštite saopštio je da je u posljednjih 12 mjeseci urađen rekordan broj dijagnostičkih testova, uz dodatnih 26 milijardi funti za Nacionalnu zdravstvenu službu (NHS).
On je, takođe, naveo da je broj pacijenata koji na vrijeme dobijaju dijagnozu ili potvrdu da nemaju rak najviši u posljednjih pet godina.
“Naš Nacionalni plan za borbu protiv raka predviđa bržu dijagnozu, ranije liječenje i bolju podršku pacijentima, sa ciljem da do 2035. godine 75 odsto pacijenata živi bez bolesti ili sa dobrim kvalitetom života pet godina nakon dijagnoze”, navodi se u saopštenju.
Dodaje se i da će Zakon o duvanu i vejpovima, koji uskoro stupa na snagu, pomoći u zaštiti budućih generacija od raka.





